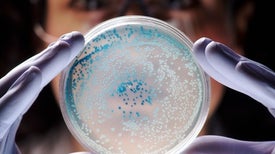

New Coronavirus Drug Shows Promise in Animal Tests
Slated for human trials, EIDD-2801 could become the first pill for COVID-19

Journalist Michael Waldholz led a team of reporters who were awarded a Pulitzer Prize in 1997 for their coverage of AIDS. He lives in New York State’s Hudson Valley. Credit: Nick Higgins

Slated for human trials, EIDD-2801 could become the first pill for COVID-19

Many new drugs trigger an immune reaction that cripples them—and the race is on to thwart the attack
Bacteria face trade-offs when optimizing traits involved in antibiotic resistance

By reprogramming DNA inside harmful microbes, biologists are turning them into patient-saving drugs

With no time to make treatments from scratch, researchers search for existing compounds that deflect harm
Support science journalism.

Thanks for reading Scientific American. Knowledge awaits.
Already a subscriber? Sign in.
Thanks for reading Scientific American. Create your free account or Sign in to continue.
Create Account